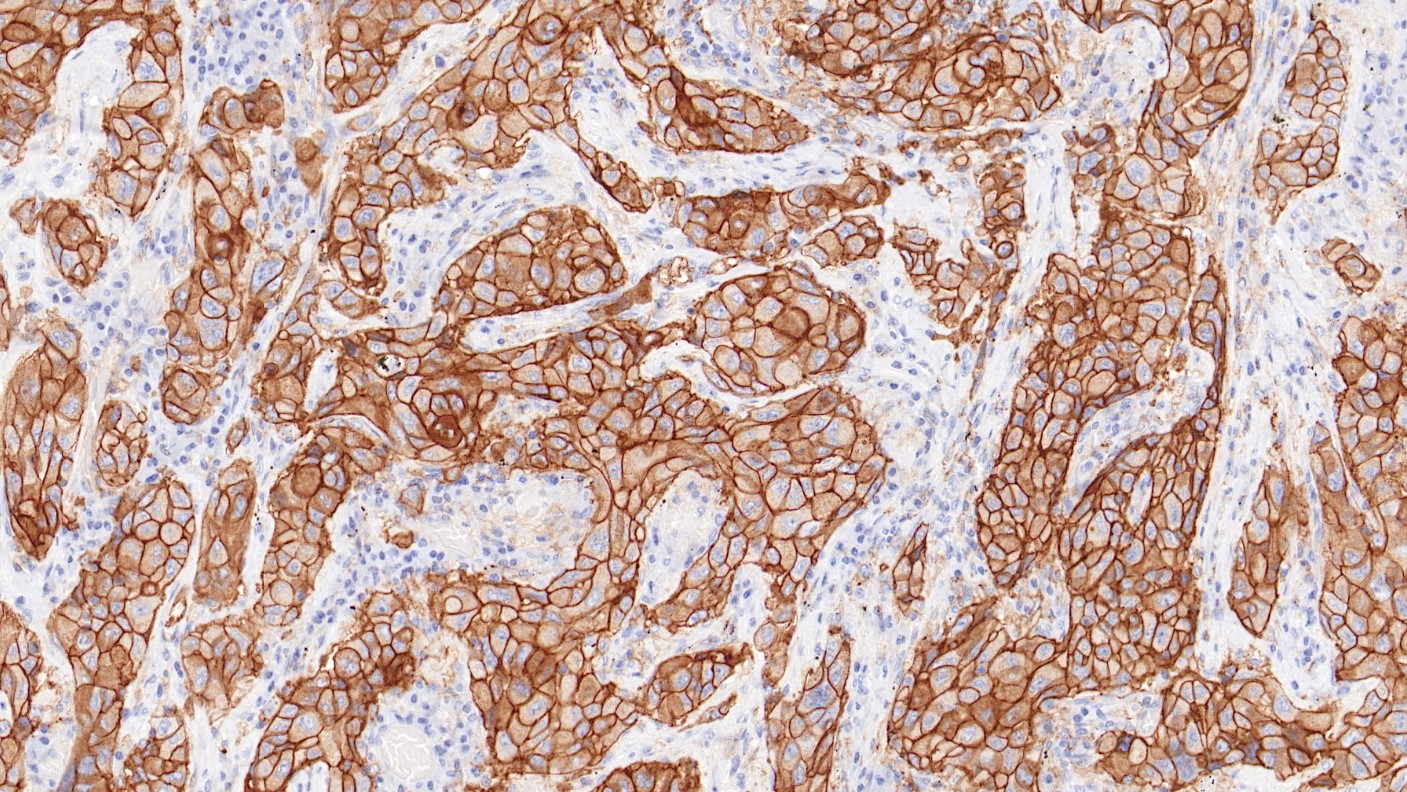
非小细胞肺癌PD-L1(BP6099)染色

产品中心

膀胱癌PD-L1(BP6099)染色
非小细胞肺癌PD-L1(BP6099)染色
PD-L1 重组兔单克隆抗体
PD-L1又称B7-H1与 PD-L2(B7-DC) 均为PD-1的受体。 PD-L1持续性表达于T细胞、 B 细胞、 巨噬细胞、 树突细胞。 当该类细胞被激活,其表达水平会升高。 大量研究证实,阻止PD-1/PD-L1 分子通路有助于抗肿瘤治疗,基于该机制可开发抗肿瘤药物。 研究数据显示 PD-L1 的表达情况与该类药物的治疗效果具有相关性。
Specifications
- 产品注册名称
- PD-L1检测试剂(免疫组织化学法)
- 目录号
- I1205
- 克隆号
- BP6099
- 亚细胞定位
- 细胞膜
- 阳性对照
- 胎盘
- 修复方式
- HIER
- 组织类型
- FFPE
- 规格
- 浓缩液:0.1mL/1mL
工作液:1.5mL/7mL
- 用途
- NMPA IVD
Applicable platform
- Biolynx平台
- Leica平台
- Roche平台
- Dako平台


